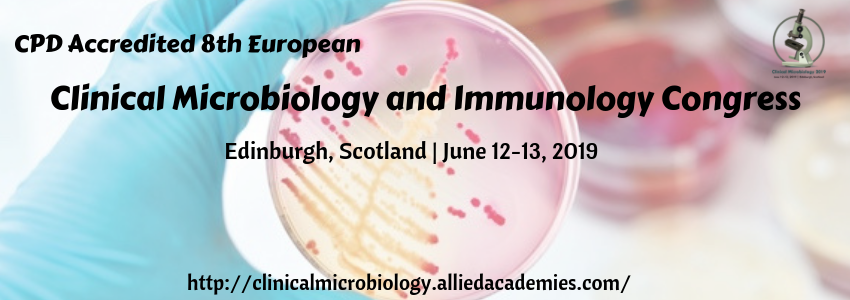

- Subscribe Now
- News
- Markets
- Auctions
- View All Auctions
- Auction Guide Zone Map
- Agriculture / Farm
- Antiques & Collectibles
- Art
- Bankruptcy
- Business & Office
- Charity / Benefit
- Consignment
- Estate
- Firearms
- Government
- Home Improvement / Lawn & Garden
- Household
- Jewelry & Watches
- Liquidation
- Machinery & Equipment
- Motors
- New Merchandise
- Online Only
- Real Estate
- Sports & Outdoor
- Surplus
- Classifieds
- Events
- Recipes
- Shop
- Subscribe Now
- News
- Markets
- Auctions
- View All Auctions
- Auction Guide Zone Map
- Agriculture / Farm
- Antiques & Collectibles
- Art
- Bankruptcy
- Business & Office
- Charity / Benefit
- Consignment
- Estate
- Firearms
- Government
- Home Improvement / Lawn & Garden
- Household
- Jewelry & Watches
- Liquidation
- Machinery & Equipment
- Motors
- New Merchandise
- Online Only
- Real Estate
- Sports & Outdoor
- Surplus
- Classifieds
- Events
- Recipes
- Shop
Get Farm and Dairy Delivered to Your Home
52 Issues as low as $33.95 or 104 Issues for only $72.95 Secure Online Ordering
About Farm and Dairy Newspaper
Company Links
- Advertising Rates
- Privacy Policy
- FAQ
- About Us
- Contact Us
- Place a Classified Ad
- Subscribe Online
- Comment Policy
Toll-Free 800-837-3419
Local 330-337-3419
Connect with us
4 Information Packed Sections!

Farm and Dairy Cover Section
Farm and Agriculture News, Local Market Prices and Crop Reports, Columns and Commentary.
Weekly Auction Guide
Hundreds of Auction Advertisements for Ohio, Pennsylvania and West Virginia.
Antique Collector
Featuring Specialty Antique Auctions, Stores and Shows
Rural Marketplace
Hundreds of Classifieds, Autos & Real Estate Listings
© 2025 Farm and Dairy is proudly produced in Salem, Ohio
© Copyright 2024 - Farm and Dairy: ISSN 0014-7826 (Print) ISSN 2993-5334 (Online)